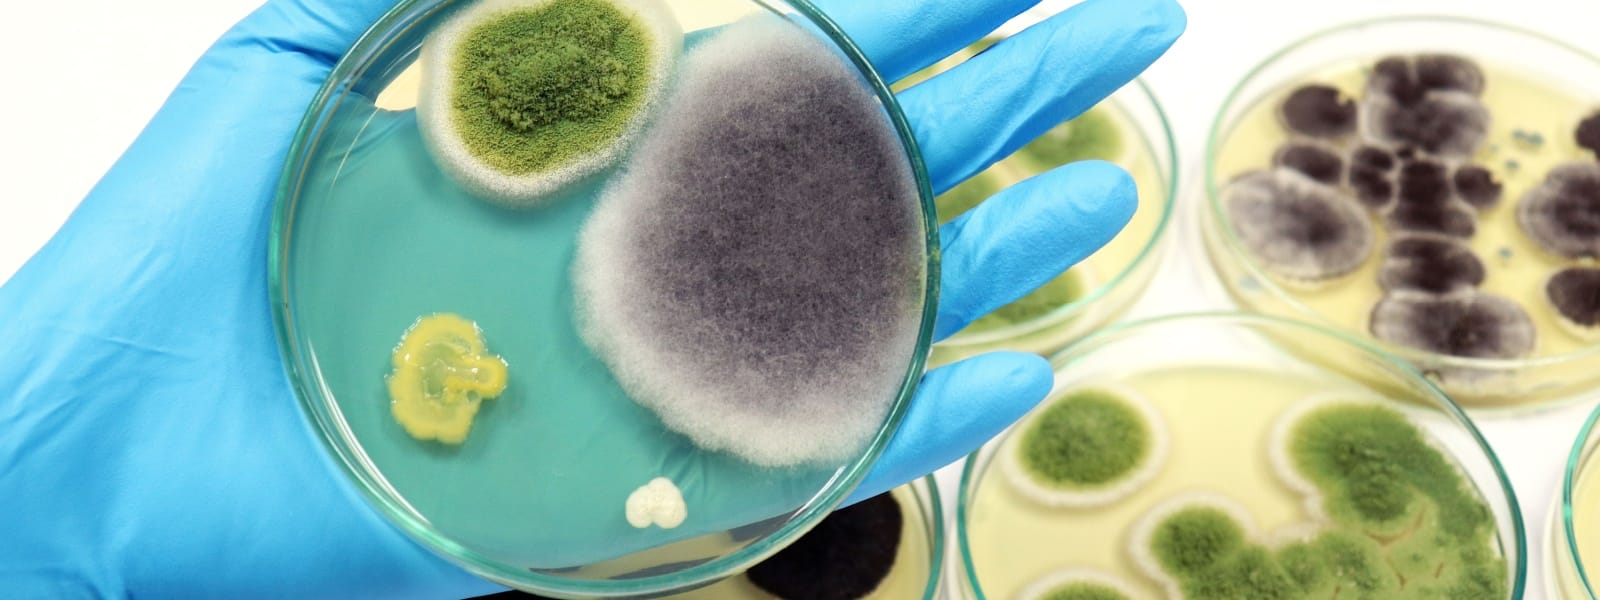
Residential Mold Testing Washington IL

Residential Mold Testing Washington IL isn’t just a service. It’s a necessity for the area we live in. Mold thrives in the damp, humid climate of Washington, IL. Especially near the Illinois River, where moisture levels soar. But mold doesn’t just stain walls. It invades your air, your lungs, your life. Golden Environmental, LLC offers expert Residential Mold Testing Washington IL to detect these hidden threats. Protect your home. Protect your family.
Why Mold Testing Matters
Mold is silent. It’s sneaky. It hides where you can’t see—in walls, under floors, in your HVAC system. The damp climate of Washington, IL makes homes here especially vulnerable. Mold spores spread through the air, infiltrating every corner of your home. Breathing in these spores can lead to respiratory issues, allergies, even chronic illnesses. Residential Mold Testing by Golden Environmental, LLC isn’t just about finding mold. It’s about finding the source, cutting it off, and protecting your health.
The Science Behind Mold Growth
Mold needs three things: moisture, warmth, and food. Washington, IL provides all three. The Illinois River boosts humidity. Summer heat traps moisture in your walls and floors. Organic materials like wood and drywall are perfect breeding grounds. Mold spores are always present in the air, but when they land on a damp surface, they colonize fast. Within 48 hours, mold can take hold, spreading and releasing more spores into the air. Without Residential Mold Testing Washington IL, you may never know it’s there until it’s too late.
Hidden Dangers Residential Mold Testing Washington IL
Not all mold is visible. It lurks behind wallpaper, under carpets, inside your ducts. Out of sight, out of mind? Think again. Mold doesn’t just affect your home’s appearance—it affects your health. Especially for those with conditions like PANS/PANDAS, Lyme disease, CIRS, or autoimmune disorders. Even small amounts of mold can trigger severe reactions. We find mold where it hides. We ensure your home is safe.
Custom Testing for Washington’s Unique Homes
No two homes are alike, especially in Washington, IL. Older homes may have hidden leaks, outdated insulation, or previous water damage. Newer homes, though built to modern standards, can still suffer from poor ventilation or faulty construction. That’s why Residential Mold Testing Washington IL is crucial. Golden Environmental, LLC tailors our testing to your home’s specific needs, considering its age, location, and history. We use advanced methods to detect mold, no matter where it’s hiding.
Real Risks, Real Solutions
Mold is a serious threat. Left unchecked, it can cause structural damage, leading to expensive repairs. But the real danger is to your health. Mold exposure can lead to chronic respiratory issues, headaches, fatigue, and more. Don’t wait until it’s too late. Residential Mold Testing Washington IL by Golden Environmental, LLC identifies mold early, giving you the power to act before it spreads. We don’t just find mold—we help you eliminate it.
Why Choose Golden Environmental, LLC?
Golden Environmental, LLC brings expertise. Our Council Certified Microbial Consultant, Ben Kunze, knows mold. He knows how to find it, test for it, and advise on removing it. We don’t just offer a service—we offer peace of mind. With our in-depth knowledge of Washington’s unique climate challenges, we provide the most thorough, reliable mold testing available.
The Testing Process
When you choose Residential Mold Testing with Golden Environmental, LLC, you’re choosing precision. We start with a detailed inspection, identifying potential problem areas. Then, we collect air and surface samples, targeting areas where mold likes to hide. These samples are analyzed in a certified lab, ensuring accurate, reliable results. Finally, we provide you with a full report, detailing our findings and recommending next steps. And we don’t stop there—we guide you through the entire process, ensuring your home is mold-free.
Take Action Now
Mold is a threat you can’t afford to ignore. Residential Mold Testing Washington IL is the first step in protecting your home and your health. Don’t wait. Contact Golden Environmental, LLC today at (815) 830-9095 to schedule your mold inspection. Your home deserves the best. Your family deserves safety. Will you take action?

